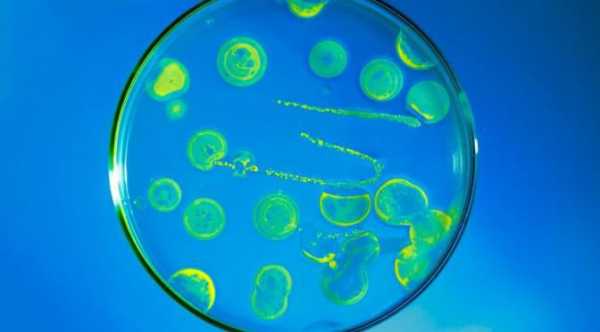

Бактерии колиформные в воде. Термотолерантные колиформные бактерии
Бактерии колиформные всегда присутствуют в пищеварительном тракте животных и человека, а также в отходах их жизнедеятельности. Они также могут находиться на растениях, почве и в воде, загрязнение которой является серьезной проблемой из-за возможности заражения заболеваниями, вызванными различными патогенами.
Вред для организма
Являются ли бактерии колиформные вредными? Большинство из них не вызывают заболеваний, тем не менее, некоторые редкие штаммы кишечной палочки могут вызвать серьезные заболевания. Кроме людей, могут быть заражены овцы и крупный рогатый скот. Вызывает беспокойство то, что зараженная вода по своим внешним характеристикам ничем не отличается от обычной питьевой по вкусу, запаху и внешнему виду. Бактерии колиформные встречаются даже в колодезной воде, которую принято считать безупречной во всех смыслах. Проверка является единственным надежным способом узнать о наличии болезнетворных бактерий.

Что происходит при обнаружении?
Что делать, если бактерии колиформные или любые другие обнаруживаются в питьевой воде? В этом случае понадобится ремонт или модификация системы водоснабжения. При употреблении для дезинфекции предусмотрено обязательное кипячение, а также повторное тестирование, которое может подтвердить, что загрязнение не было устранено, если это были термотолерантные колиформные бактерии.

Организмы-индикаторы
Общие колиформные бактерии часто называют организмами-индикаторами, потому что они указывают на потенциальное наличие болезнетворных бактерий в воде, например, кишечной палочки. Хотя большинство штаммов являются безобидными и живут в кишечнике здоровых людей и животных, некоторые из них могут способствовать образованию токсинов, вызывать серьезные заболевания и даже приводить к летальному исходу. Если болезнетворные бактерии присутствуют в организме, то самыми распространенными симптомами являются расстройство желудочно-кишечного тракта, лихорадка, боль в животе и понос. Симптомы более ярко проявляются у детей или пожилых членов семьи.

Безопасная вода
Если общие колиформные бактерии в воде отсутствуют, то практически с полной уверенностью можно предположить, что она микробиологически безопасна для питья.
Если же они были обнаружены, то тогда будет оправданным проведение дополнительных тестов.
Бактерии любят тепло и влагу
Температура и погодные условия также играют немаловажную роль. Например, кишечная палочка предпочитает жить на поверхности земли и любит тепло, таким образом, колиформные бактерии в питьевой воде появляются в результате движения в составе подземных потоков при теплых и влажных погодных условиях, в то время как наименьшее количество бактерий будет найдено в зимнее время года.

Ударное хлорирование
Для эффективного уничтожения бактерий используют хлор, который окисляет все примеси. На его количество будут влиять такие характеристики воды, как уровень рН и температура. В среднем, вес сухого вещества на литр составляет приблизительно 0,3-0,5 миллиграмм. Чтобы убить общие колиформные бактерии в питьевой воде, требуется примерно 30 минут. Время контакта может быть сокращено за счет увеличения дозы хлора, но для этого могут потребоваться дополнительные фильтры для удаления специфического вкуса и запаха.

Губительный ультрафиолетовый свет
Популярным вариантом дезинфекции считаются ультрафиолетовые лучи. Этот способ не подразумевает использования каких-либо химических соединений. Однако это средство не применяется там, где общие колиформные бактерии превышают одну тысячу колоний на 100 мл воды. Сам прибор состоит из УФ-лампы, окруженной рукавом из кварцевого стекла, через который протекает жидкость, облучаемая ультрафиолетовым светом. Необработанная вода внутри аппарата должна быть полностью чистой и свободной от каких-либо видимых загрязнений, засоров или мутности, чтобы дать возможность облучения всех вредоносных организмов.
Другие варианты очистки
Существует множество других способов обработки, используемых для дезинфекции воды. Однако они не рекомендуется в качестве длительных по разным причинам.
- Кипячение. При 100 градусах по Цельсию в течение одной минуты эффективно убиваются бактерии. Этот метод часто используется для дезинфекции воды во время чрезвычайных ситуаций или при необходимости. Это занимает время и является энергоемким процессом и, как правило, применяется только в небольших количествах воды. Это не долговременный или постоянный вариант для дезинфекции воды.
- Озонирование. В последние годы этот метод используется в качестве способа улучшения качества воды, устранения различных проблем, в том числе бактериального заражения. Как и хлор, озон является сильным окислителем, который убивает бактерии. Но в то же время этот газ является нестабильным, и получить его можно только с помощью электричества. Блоки озонирования обычно не рекомендуются для дезинфекции, потому что они гораздо дороже хлорирования или ультрафиолетовых систем.
- Йодирование. Некогда популярный способ дезинфекции в последнее время рекомендуется только для кратковременного или экстренного обеззараживания воды.

Термотолерантные колиформные бактерии
Это особая группа живых организмов, которые способны ферментировать лактозу при 44-45 градусах по Цельсию. К ним относят род Escherichia и некоторые виды Klebsiella, Enterobacter и Citrobacter. Если в воде присутствуют посторонние организмы, это свидетельствует о том, что она была недостаточно хорошо очищена, загрязнена повторно, либо в ней в избытке содержатся питательные элементы. При их обнаружении необходимо сделать проверку на наличие именно устойчивых к повышенной температуре колиформных бактерий.

Микробиологический анализ
Колиформные организмы принадлежат классу граммотрицательных бактерий, которые внешне напоминают палочку, они живут и размножаются в нижнем отделе пищеварительного тракта животных и человека. В целом, бактерии включают в себя множество разновидностей, опасных в той или иной степени. Микробиологический анализ включает также идентификацию всевозможных вирусов и паразитов. Микробиологический анализ проводится не только для проверки питьевой воды, но и для проверки безопасности тех водоемов, где люди с удовольствием проводят свой досуг. Некоторых, конечно, не пугает купание в воде, где была обнаружена “палочка”, однако безопасность такой воды также регламентируется. Существуют определенные гигиенические требования к состоянию поверхностных вод.
Если были обнаружены колиформы, то это может говорить о том, что в воду попали патогенные микроорганизмы. Таким образом, начинают распространяться различные заболевания. В загрязненной питьевой воде можно встретить штаммы сальмонелл, шигелл, кишечной палочки и многих других возбудителей болезней, которые варьируются от легких нарушений пищеварительного тракта до тяжелейших форм дизентерии, холеры, брюшного тифа и многих других.
Бытовые источники заражения
За качеством питьевой воды ведут наблюдение, ее регулярно проверяют специализированные санитарные службы. А что может сделать обычный человек, чтобы обезопасить себя и оградить от нежелательного заражения? Какие существуют источники загрязнения воды в бытовых условиях?
- Вода из кулера. Чем больше людей прикасаются к данному приспособлению, тем больше вероятность проникновения вредоносных бактерий. Как показывают исследования, вода в каждом третьем кулере просто кишит живыми организмами.
- Дождевая вода. Как это ни удивительно, собранная после дождя влага является благоприятной средой для развития колиформных бактерий. Продвинутые садоводы не используют такую воду даже для полива растений.
- Озера и водоемы также относят к группе риска, так как в стоячей воде быстрее размножаются все живые организмы, а не только бактерии. Исключением можно назвать океаны, развитие и распространение там вредоносных форм минимально.
- Состояние трубопровода. Если сточные трубы не менялись и не очищались продолжительное время, то это может также привести к появлению неприятностей.
fb.ru
Колиформные бактерии что это такое
Термотолерантные колиформные бактерии
Бактерии этого типа представляют собой группу колиформных организмов. способных ферментировать лактозу при 44 – 45 о С и включают род Escherichia (более известный как E.Coli ) и в меньшей степени отдельные виды Klebsiella, Enterobacter и Citrobacter.
Термотолерантные колиформные бактерии поддаются быстрому обнаружению и поэтому играют важную вторичную роль при оценке эффективности очистки воды от фекальных бактерий. Более точным индикатором служит именно E.Coli (кишечная палочка), так как источником некоторых других термотолерантных колиформ могут служить не только фекальные воды. Именно поэтому часто используемый термин фекальные колиформы некорректен и ВОЗ не рекомендует им пользоваться применительно к термотолерантным колиформным микроорганизмам.
Однако полная идентификация E.Coli слишком сложна для рутинных исследований. В то же время общая концентрация термотолерантных колиформ в большинстве случаев прямо пропорциональна концентрации E.Coli, а их вторичный рост в распределительной сети маловероятен (за исключением случаев наличия в воде достаточного количества питательных веществ, при температуре выше 13 о С и отсутствии остаточного хлора). Все это делает использование термотолерантных колиформных бактерий в качестве индикатора загрязнения воды весьма практичным.
ВОЗ рекомендует национальным контрольным лабораториям производить точное определение E.Coli в случаях обнаружения большого количества термотолерантных бактерий (при отсутствии санитарных аварий), либо, наоборот, в условиях, когда возможности комплексных микробиологических исследований ограничены.
Колиформные организмы (общие колиформы)
Колиформные организмы являются удобными микробными индикаторами качества питьевой воды и в этом качестве применяются уже много лет. Связано это, в первую очередь, с тем, что они легко поддаются обнаружению и количественному подсчету.
Термин Колиформные организмы (или колиформные бактерии ) относится к классу граммотрицательных бактерий, имеющих форму палочек, в основном живущих и размножающихся в нижнем отделе пищеварительного тракта человека и большинства теплокровных животных (например, домашнего скота и водоплавающих птиц) и способных ферментировать лактозу при 35-37 о С с образованием кислоты, газа и альдегида. В воду попадают, как правило, с фекальными стоками и способны выживать в ней в течение нескольких недель, хотя и лишены (в подавляющем большинстве) способности к размножению.
Исследования последних лет показывают, что наряду с традиционно относимыми к этому классу бактериями Escherichia (или E.Coli). Citrobacter, Enterobacter и Klebsiella (для которых справедливо все вышесказанное), к этому типу относятся и такие ферментирующие лактозу бактерии, как Enterobacter cloasae и Citrobadter freundii. Последние можно обнаружить не только в фекалиях, но и в окружающей среде (богатые питательные воды, почва, разлагающиеся растительные материалы и т.п.), а также в питьевой воде с относительно высокой концентрацией питательных веществ. Кроме того, сюда же относятся и виды, которые редко или совсем не обнаруживаются в фекалиях и могут размножаться в воде достаточно хорошего качества.
Вышесказанное означает, что возможности применения этой группы в качестве индикатора фекального загрязнения вод ограничено. Тем не менее, хотя колиформные организмы не всегда напрямую связаны с наличием в воде патогенных агентов, колиформный тест вполне применим для контроля микробиологического качества очистки воды, подаваемой в системы водоснабжения.
Согласно рекомендациям ВОЗ, колиформные бактерии не должны обнаруживаться в системах водоснабжения с подготовленной водой. Допускается случайное попадание колиформных организмов в распределительной системе, но не более чем в 5% проб, отобранных в течение любого 12-месячного периода при условии отсутствия E.Coli. Присустствие же колиформных организмов в воде свидетельствует о ее недостаточной очистке, вторичном загрязнении или о наличии в воде избыточного количества питательных веществ. При их обнаружении обязательным является тест на наличие термотолерантных колиформных бактерий (и/или E.Coli).
Бактериологические и паразитологические показатели качества воды – общие колиморфные бактерии
Консультанты
Антон Бударагин Консультант E-mail:[email protected] Тел.:(831)216-43-00 доб.129
Дмитрий Горащенков Консультант E-mail:[email protected] Тел.:(831)216-43-00 доб.104
Александр Осетров Консультант E-mail:[email protected] Тел.:(831)216-43-00 доб.131
Колиформные бактерии в воде
Для того, чтобы пить чистую воду, ее нужно, прежде всего, оценить на пример содержания разного рода включений. Даже вода из крана, может бать заражена бактериями. И причина тому, плохое состояние системы водоснабжения. Очень часто в воде, особенно неочищенной сегодня можно встретить всякого рода бактерии. А для того, чтобы вода стала питьевой, колиморфные бактерии в воде следует уничтожать.
Не должно быть в 20 мг воды
Как наглядно видно из таблицы, бактерий, практически не должно быть в воде. Любое присутствие колиформных бактерий в воде или каких других, может вызвать массовые эпидемии. Потому и поставлен запрет на их присутствие. Это может привести к летальному исходу многих людей.
Весь перечень вредных бактерий довольно обширен. Выявить все вредные бактерии в воде сложно, потому и придумали более современные методы анализов – химико-бактериологический, который и помогает выявить вредные палочные бактерии, в том числе. Эти вредоносные примеси можно выявить только в лаборатории. На вкус, цвет и вид выявить их невозможно.
Появляются такие бактерии в любом теплокровном существе. В том числе в кишечнике животных или человека. Откуда же они берутся в воде? Все просто, если в воду попадают фекалии, то развитие таких вредоносных бактерий очень возможно.
Фекалии же могут проникать в воду из сточных канав, выгребных ям, фильтровых траншей. Проявиться они могут даже в колодце. из-за смещения слоев грунта. Человек же эксплуатирующий колодец, может этого и не заметить. Потому и рекомендуют через время делать анализ воды в колодце, если нет качественной очистной системы на участке.
По санитарным нормам колиформных бактерий в воде не должно быть совсем. Потому на станциях водоснабжения всегда есть этап обеззараживания, который как раз и занимается устранением вредных бактериологических примесей.
Наиболее популярными вариантами устранения бактерий из воды являются обеззараживающие установки. Можно конечно и вручную дозировать дезинфицирующие вещества. Но это чревато плохими последствиями. Из-за этого на производствах давно убрали ручной труд в работе обеззараживающих установок.
Для устранения бактериологической угрозы на предприятиях используют дозирование химических веществ. Если вода будет использоваться для питья, то в этом случае применяют ультрафиолетовые дезинфекторы, которые работают без вредных веществ.
О бактериях научным языком и более подробно
Колиформные бактерии называются еще очень вредными. Это группа одна из самых вредных групп бактерий. Из семейства энтеробактерий, группу палочки культуральным признакам. Группа таких бактерий является санитарным показателем фекальных вод.
По порядку ниже будут исследованы следующие особенности поведения бактерий кишечной палочки:
- Поведение бактерий в плотной питательной среде
- Биохимические особенности
- Устойчивость
- Санитарные значения
Хотя данный вид информации довольно специфичен, но он помогает наглядно проследить все особенности работы бактерий в воде. На сколько они устойчивы, что вызывают своей работой в воде и т.д.

Итак, питательная среда. Бактерии прекрасно себя чувствуют в мясном бульоне или агаре. Осадок при этом имеет небольшие размеры, а вот рост бактерий резко идет вверх и появляется сильное помутнение воды.
Бактерии в бульене образуют окаемку, пленки при этом на поверхности нет. По цвету, большое скопление бактерий может иметь серо-голубой оттенок, иногда колонии могут быть красными с металлическим отливом. Колонии бактерий с отрицательной лактозой чаще всего бесцветны. В общем, же классифицировать по цветам и поведению бактерии группы палочки довольно сложно.
Теперь, что касается биохимических свойств. Бактерии такого рода помогают свертываться молоку, не разводят желатин. Оксидазной активности у них нет.
Расщеплять лактозу могут как раз бактерии кишечной палочки (с положительной лактозой).
Что касается устойчивости бактерий к разного рода химическим сильным дезинфекторам. Обезвредить кишечную палочку довольно просто. Для этого достаточно стандартной пастеризации при температуре 65, от силы 75 градусов. При температуре в 60 градусов по Цельсию, кишечная палочка убивается в течение 15 минут. Однопроцентный раствор фенола убирает палочку за период от 5 до 15 минут. Если разводить сулему в пропорциях один к тысячи, то тогда палочка будет убрана за 2 минуты. То есть убрать такие бактерии – не проблема.
Санитарные показатели бактерий кишечной палочки имеют разные значения. Если бактерии такого рода обнаруживаются на фруктах овощах в воде или почве, это означает только одно – свежее фекальное загрязнение имеет место.
Что характерно, в желудке человека, если он долгое время применяет антибиотики, тоже образуются бактерии кишечной палочки. Лактозоотрицательные бактерии в состоянии сбродить лактозы, именно они и образуются в большом количестве в кишечнике. Так образуются брюшной тиф, дизентерия, как раз те болезни, которые проявляют себя при употреблении зараженной кишечной палочкой воды.
Из всего вышесказанного, можно сделать вывод. Колиформные бактерии в воде должны полностью отсутствовать. Наличие их в воде угрожает эпидемиями и массовыми смертями. Чтобы избежать массового заражения, нужно постоянно следить за составом воды. Изменение потоков подземных вод, может привести к образованию грязных потоков.
Устранить колиформные бактерии из воды можно всего двумя способами. Использовать либо дезинфекцию, либо обеззараживание. Разница в понятиях состоит в воздействии. Оно может быть химическим, а может быть физическим. Для очистки сточных вод может использоваться химическое воздействие с помощью хлорсодержащих элементов. Но в этом случае обязательно должна проходить доочистка. Чтобы устранить из воды излишек хлора, который так же негативно влияет на здоровье человека.
Остальные варианты производства питьевой воды используют ультрафиолетовые излучатели, которые убивают группу бактерий кишечной палочки с помощью ультрафиолета. Не облучая при этом воду вредными лучами и не оставляя после себя следов.
Еще один вариант дезинфекции использование озона – концентрированного жидкого кислорода. Он быстро испаряется с поверхности воды, отлично чистит ее и не имеет остаточных явлений в воде. Полностью экологически безопасен. Но труден в производстве и дорог.
Бактерии в нашей воде
В разделе: Вода | и в подразделах: дезинфекция. | Автор-компилятор статьи: Лев Александрович Дебаркадер
Ранее, в разделе Вода и подразделе Дезинфекция мы затронули вопросы обеззараживания воды (например, в статье Реагентное обеззараживание воды ). И, кроме того, мы начали интересную тему, посвящённую тем, от кого мы обеззараживаем воду (см. статью Болезнь легионеров (легионеллёз) ). Но существует намного больше бактерий, которые живут в воде и от которых нужно защититься с помощью, например, ультрафильтрации. Поэтому наша сегодняшняя тема #8212 бактерии в нашей воде. Где мы расскажем немножко про то, какие бактерии не должны жить в нашей воде.
Бактерии в нашей воде #8212 это нежелательное явление по ряду причин, которые мы рассмотрим далее. Бактерии в целом определяются с помощью микробиологического анализа воды, и выражаются общим микробным числом с единицей измерения колоний образующие единицы , к.о.е. (или к.у.о на украинском языке, colony forming units #8212 CFU на английском языке).

Общее микробное число отражает общий уровень содержания бактерий в воде, а не только тех из них, которые образуют колонии, видимые невооруженным глазом на питательных средах при определенных условиях культивирования.
Бактерии в целом, выраженные общим микробным числом, включают несколько групп и подгрупп бактерий. Это:
- Колиформные бактерии (в том числе термотолерантные).
- Сульфитредуцирующие клостридии.
Кстати, в микробиологический анализ воды входит и определение вирусов (колифаги, вирусы, которые подавляют бактерий), и определение паразитов (например, лямблий).
Пара слов про клостридий. Клостридии #8212 это своеобразный эталон. Они очень живучи, или если по научному, устойчивы к обеззараживанию, что делает их своеобразным показателем – отсутствуют клюстридии, отсутствуют и другие, даже более опасные микроорганизмы.

И, наконец, обратим внимание на наиболее распространённый показатель #8212 на колиформные бактерии как один из камней преткновения при микробиологическом анализе воды.
Камень преткновения, кстати, состоит в том, что часто считается, что это болезнетворные бактерии, и если глотнуть такой водички, то дезинтерия или холера начинается почти сразу. Но по отношению к колиформным бактериям это не совсем так. Согласно определению из словаря,
Колиформные бактерии #8212 это бактерии группы кишечной палочки (БГКП, также называются колиморфными и колиформными бактериями) — условно выделяемая по морфологическим и культуральным признакам группа бактерий семейства энтеробактерий, используемая санитарной микробиологией в качестве маркера фекальной контаминации
На нормальном языке это означает, что все бактерии, похожие чем-то на бактерию Кишечная палочка (Escherichia coli, по имени Теодора Эшериха сокращённо E.coli), обЪединены в одну группу, названную колиформные бактерии , то есть, бактерии, похожие на E.coli . Кроме того, колиформные организмы являются удобными микробными индикаторами качества питьевой воды и в этом качестве применяются уже много лет. Связано это, в первую очередь, с тем, что они легко поддаются обнаружению и количественному подсчету.
Термин Колиформные организмы (или колиформные бактерии ) относится к классу граммотрицательных бактерий, имеющих форму палочек, в основном живущих и размножающихся в нижнем отделе пищеварительного тракта человека и большинства теплокровных животных (например, домашнего скота и водоплавающих птиц). Следовательно, в воду они попадают, как правило, с фекальными стоками и способны выживать в ней в течение нескольких недель, хотя и лишены (в подавляющем большинстве) способности к размножению.
- Соответственно, если данные бактерии находятся в питьевой воде, то это значит, что есть вероятность загрязнения воды сточными водами.
- Ну и во-вторых, если среди колиформных бактерий есть вирулентные штаммы (болезнетворные разновидности) бактерий, то возможно и возникновение заболеваний.
Кроме того, среди колиформных бактерий часто определяется ещё одна группа- термотолерантные колиформные бактерии. Это бактерии, которые похожи на Кишечную палочку , и способны переваривать пищу при более высоких температурах (44 #8212 45 о С) и включают собственно род Escherichia (более известный как E.Coli) и некоторые другие.
Термотолерантные колиформные бактерии выделяются в отдельную подргуппу в микробиологическом анализе, поскольку свидетельствуют о недавнем фекальном загрязнении. Кроме того, их относительно просто определить #8212 поэтому почему бы и не включить их в результаты анализа?
Как бы то ни было, любое повышенное содержание бактерий в воде #8212 это тревожный признак, и при его появлении нужно что-то делать с водой (например, начинать использовать фильтры ).

Итак, мы сделали общий теоретический обзор бактерий в нашей воде, и можем перейти к практике.
Иногда возникает такая ситуация: кто-то хочет провести микробиологический анализ воды. Отбирает пробу воды, относит в санэпидемстанцию, а там#8230 Тысячи и тысячи бактерий. Проблема состоит в том, что это не значит, что в исходной воде эти бактерии были. На самом деле есть три варианта их появления в пробе воды:
- бактерии действительно присутствуют в воде
- занесены в процессе монтажа оборудования и трубопроводов
- имел место неправильный отбор проб на микробиологию.
Для того, чтобы исключить третью причину избыточного количества бактерий в воде, нужно правильно отбирать пробу воды. Соответственно, предлагаем вашему вниманию важные правила по правильному отбору пробы воды для микробиологического анализа. Так, нужно:
- Использовать только бутылку предварительно обеззараженную в автоклаве.
- Перед отбором пробы помыть руки мылом.
- Носик крана, из которого будет произведен отбор, пробы необходимо протереть спиртом или обжечь пламенем от зажигалки или спички.
- Наполненную до верху водой бутылку отвезти в лабораторию как можно быстрее (например, в течение двух часов).
Поэтому можно сделать вывод: бактерий не должно быть в воде не только потому что они могут привести к болезням, а и потому что они #8212 индикатор загрязнения воды побочными продуктами (например, слишком много органики, фекальные воды и т.д.). Другими словами, эти данные не имеют большого значения для обнаружения фекального загрязнения и не должны считаться важным показателем при оценке безопасности систем питьевого водоснабжения, хотя внезапное увеличение числа колоний при анализе воды из подземного водоисточника может служить ранним сигналом загрязнения водоносного горизонта.
Соответственно, бактерии в нашей воде #8212 это не то, что там должно быть

Источники:
sferatd.ru
Определение общих и термотолерантных колиформных бактерий методом мембранной фильтрации
К общим колиформным бактериям относятся грамотрицательные не образующие спор палочки, не обладающие оксидазной активностью, ферментирующие лактозу или маннит с образованием альдегида, кислоты и газа при температуре 37°С в течение 24-48 часов. Общие колиформы представляют широкую группу микроорганизмов семейства Enterobacteriaceae, включающую наряду с E. coli микроорганизмы родов Klebsiella, Enterobacter, Citrobacter, которые также могут находиться в кишечнике. Колиформный тест применяется как индикатор очистки и санитарного состояния водоснабжения. Обнаружение общих колиформных бактерий свидетельствует о недостаточной очистке воды.
Термотолерантные колиформные бактерии обладают всеми признаками общих колиформных бактерий, которые также способны ферментировать лактозу до кислоты, альдегида и газа, но при температуре 44°С в течение 24 часов. В группу термотолерантных колиформных бактерий входит род Escherichia, а также отдельные виды родов Klebsiella, Enterobacter, Citrobacter. Термотолерантные колиформные бактерии рассматриваются как показатели фекального загрязнения.
Метод основан на фильтрации установленного объёма воды через мембранные фильтры, выращивании посевов на селективной питательной среде с лактозой и последующей идентификации колоний по культуральным и биохимическим свойствам.
Для качественного анализа используют воду в объёме 100 мл. Этот объём воды фильтруют через нитроцеллюлозный мембранный фильтр. Для этих целей используют фильтры с диаметром пор 0,45 мкм. Перед фильтрованием фильтр помещают в дистиллированную воду и кипятят 15-20 минут. Обработанный таким образом фильтр помещают блестящей поверхностью вниз на сетку фильтра Зейтца, вставленного в колбу Бунзена. В воронку наливают исследуемый объём воды и фильтруют с помощью водоструйного насоса или аппарата Комовского. После фильтрования фильтр переносят стерильным пинцетом на чашку Петри со средой Эндо. Чашки с фильтрами помещают на сутки в термостат дном вверх и инкубируют посевы при температуре 37°С (определение общих колиформных бактерий).
Для определения термотолерантных бактерий посев инкубируют при температуре 44°С в течение 24 часов.
Учёт результатов.
Результат считается отрицательным, если на фильтрах нет роста колоний или отмечен рост пленчатых, губчатых, плесневых, прозрачных и расплывчатых колоний. При наличии типичных лактозоположительных колоний, дающих отпечаток на обратной стороне мембранного фильтра и среде – темно-красных, красных с металлическим блеском и без него, выпуклых с красным центром и других оттенков, а также лактозоотрицательных – розовых без отпечатков, подсчитывают число колоний каждого типа.
Для идентификации отбирают колонии каждого вида, делают их посев на скошенный МПА или на чашки секторами, инкубируют при температуре 37°С 16-18 часов.
Все дальнейшие биохимические тесты проводят только с чистыми культурами.
В качестве подтверждающих тестов используют оксидазный тест и тест образования кислоты и газа при ферментации лактозы или маннита.
Тест на оксидазную активность проводят с помощью системы индикаторной бумажной (СИБ). СИБ для определения оксидазной активности представляет собой хроматографическую бумагу, пропитанную растворами диметил-парафенилендиамина и α-нафтола. Цвет индикаторных полосок серовато-фиолетовый.
Механизм реакции: оксидаза, продуцируемая микроорганизмами, обуславливает взаимодействие между диметил-парафенилендиамином и
α-нафтолом, при этом образуется индофенол синий, окрашивающий культуру в синий цвет.
Постановка оксидазного теста: часть изолированной колонии изучаемой культуры петлей наносят на пропитанную реактивом фильтровальную бумагу, помещенную в чашку Петри. Если в течение 1 мин. появляется фиолетово-коричневое окрашивание, культура считается оксидазоположительной и дальнейшему изучению не подлежит. Если реакция на оксидазу отрицательная (цвет на месте нанесения культуры не меняется), культура подлежит дальнейшему исследованию. Оксидазоотрицательные колонии засевают в пробирки с полужидкой лактозной средой.
Полужидкая среда с лактозой или маннитом (глюкозой): в 1 л дистиллированной воды растворяют 10 г пептона, 5 г NaCl, 4-5 г агар-агара, доводят до кипения, устанавливают рН 7,2-7,4, добавляют 1 мл 1,6% спиртового раствора бромтимолового синего. Стерилизуют при 120°С 20 минут. В расплавленную среду вносят 5 г лактозы или маннита (глюкозы), нагревают до кипения, разливают в стерильные пробирки на высоту 3-5 см и стерилизуют при 112°С 10 минут. Правильно приготовленная среда – зеленого цвета с синеватым оттенком (цвет бутылочного стекла).
Посев производят уколом до дна пробирки. При образовании кислоты цвет среды изменяется в жёлтый, при газообразовании газ скапливается или по уколу, или на поверхности, или в толще среды появляются разрывы.
Для определения общих колиформных бактерий посев инкубируют при 37°С, для определения термотолерантных колиформных бактерий посев инкубируют при 44°С в течение 24 часов.
Грамотрицательные колонии учитывают как общие колиформные бактерии при отрицательном оксидазном тесте, ферментации лактозы при температуре 37°С с образованием кислоты и газа. Грамотрицательные колонии учитывают как термотолерантные колиформные бактерии при отрицательном оксидазном тесте и ферментации лактозы при температуре 44°С с образованием кислоты и газа.
megaobuchalka.ru
Петритест – микробиологические экспресс-тесты – 18.3. Методы определения общих и термотолерантных колиформных бактерий в воде
Общие колиформные бактерии (ОКБ) – это грамотрицательные, оксидазоотрицательные палочки, не образующие спор, растущие на дифференциальных лактозных средах, ферментирующие лактозу до кислоты, альдегида и газа при температуре 37±1 °С в течение 24–48 ч. Термотолерантные колиформные бактерии (ТКБ) входят в число ОКБ, обладают всеми их признаками и, кроме того, способны ферментировать лактозу до кислоты, альдегида и газа при температуре 44±0,5 °С в течение 24 ч.
ОКБ и ТКБ в воде, согласно действующим МУ 2.1.4.1018–01, определяют мембранным и титрационным (бродильным) методами. Титрационный метод используют только при отсутствии материалов и оборудования, необходимых для выполнения анализа методом мембранной фильтрации, наличии в воде большого количества взвешенных веществ и в случае преобладания посторонней микрофлоры, препятствующей получению на фильтрах изолированных колоний.
18.3.1. Определение общих и термотолерантных колиформных бактерий методом мембранной фильтрации
Сущность метода заключается в концентрировании бактерий из определенного объема воды на мембранных фильтрах с подращиванием их на среде Эндо при 37±1,0 °С, дифференцировании по культуральным и биохимическим тестам и подсчете выросших колоний.
Первый день. 1. Подготовка мембранных фильтров. Мембранные фильтры с диаметром пор не более 0,45 мкм и размером диска 35 или 47 мм (ацетатцеллюлозные, нитратцеллюлозные, ядерные и др.), имеющие сертификат качества, выпускаются стерильными, в противном случае их стерилизуют методом кипячения по инструкции, предложенной изготовителем.
- Подготовка фильтровального аппарата. Фильтровальный аппарат, воронку и столик фильтровального аппарата обтирают и фламбируют марлевым (ватным) тампоном, смоченным спиртом. После охлаждения на столик фильтровального аппарата кладут фламбированным пинцетом стерильный мембранный фильтр, прижимают его воронкой. Если вода содержит большое количество взвешенных веществ или клеток, ее сначала фильтруют через фильтр с большим диаметром пор, помещая его поверх основного фильтра с диаметром пор 0,45 мкм.
- Фильтрование воды. В воронку прибора для фильтрования наливают отмеренный объем воды, затем создают вакуум. При посеве нескольких объемов одной пробы следует фильтровать через один фильтровальный аппарат без обеззараживания сначала меньшие, а затем большие объемы воды, меняя каждый раз фильтры. Перед фильтрованием каждой новой пробы прибор обеззараживают. Вначале фильтруют пробы обеззараженной воды или предположительно незагрязненные, а затем фильтруют загрязненные пробы. При фильтровании 1 мл исследуемой воды в воронку наливают предварительно не менее 10 мл стерильной воды, а затем вносят анализируемую воду.
После окончания фильтрования и осушения фильтра отключают вакуум, воронку снимают, фильтр осторожно поднимают за край фламбированным пинцетом и переносят его, не переворачивая, на питательную среду Эндо (рецепты 96, 97), разлитую в чашки Петри, избегая пузырьков воздуха между средой и фильтром. Поверхность фильтра с осевшими на ней бактериями должна быть обращена вверх.
Под каждым фильтром на дне чашки делают надпись с указанием объема профильтрованной воды, номера пробы и даты посева. На одну чашку помещают 3–4 фильтра с условием, чтобы фильтры не соприкасались. Чашки с фильтрами ставят в термостат дном вверх и инкубируют посевы при температуре 37±1 °С в течение 24±2 ч.
При исследовании питьевой воды анализируют 3 объема по 100 мл. При получении стабильных отрицательных результатов допустима фильтрация 300 мл воды через один фильтр.
Объем воды водоемов для посева выбирают в зависимости от степени ее предполагаемого загрязнения. Рассчитывают, чтобы не менее чем на двух фильтрах выросли изолированные колонии. Из них не более 30 колоний на фильтрах диаметром 35 мм или не более 50 колоний на фильтрах диаметром 47 мм должны быть образованы колиформными бактериями. При этом можно ориентироваться на результаты предыдущих исследований.
При исследовании воды неизвестной степени бактериального загрязнения следует засевать не менее четырех-десяти-кратных ее объемов.
Так, например, для воды водоемов, загрязняемых сточными водами, рекомендуется брать объемы 10; 1; 0,1; 0,01 мл. При анализе воды водоемов в зоне влияния выпуска сточных вод – 0,1; 0,01; 0,001; 0,0001 мл; для чистых водоемов – 100; 50; 10; 1 мл. При анализе воды незагрязненных шахтных колодцев фильтруют 100; 10; 1 и 0,1 мл.
Второй день. По окончании инкубации производят просмотр посевов:
- • отсутствие микробного роста или обнаружение колоний, не характерных для ОКБ (пленчатые, губчатые, плесневые, прозрачные, расплывчатые), позволяет на этом этапе анализа закончить исследования с выдачей отрицательного результата (отсутствие ОКБ и ТКБ в исследуемом объеме воды). Анализ заканчивают через 24 ч;
- • при обнаружении на фильтрах типичных лактозоположительных колоний (темно-красных, красных с металлическим блеском или без него либо других подобного типа колоний с отпечатком на обратной стороне фильтра) исследования продолжают. Подсчитывают число колоний каждого типа отдельно и приступают к подтверждению их принадлежности к ОКБ и ТКБ.
Каждую выбранную изолированную колонию исследуют на наличие оксидазной активности (см. гл. 9, рецепт 75). Оксидазный тест предложен для дифференциации бактерий семейства Enterobacteriaceae от грамотрицательных бактерий семейства Pseudomonadaceae и других водных сапрофитов, которые в отличие от кишечных бактерий вырабатывают фермент оксидазу.
Готовят мазки, окрашивают их по Граму, микроскопируют или определяют принадлежность к грамотрицательным бактериям постановкой теста Грегерсена, не требующего использования оптики (см. гл. 6). Подтверждают ферментацию лактозы до кислоты и газа.
Оставшуюся часть оксидазоотрицательной грамотрицательной изолированной колонии засевают параллельно в две пробирки с лактозной средой (рецепт 99).
- — для подтверждения наличия ОКБ посев инкубируют при температуре 37±1 °С в течение 48 ч;
- — для подтверждения наличия ТКБ посев осуществляют в среду, предварительно прогретую до температуры 43–44 °С, и инкубируют при температуре 44±0,5 °С в течение 24 ч.
Первичный учет образования кислоты и газа на подтверждающих полужидких средах и СИБ-лактозы (коммерческие полоски) возможен через 4–6 ч. При обнаружении кислоты и газа в среде с лактозой дают положительный ответ. При отсутствии кислоты и газа или при наличии только кислоты пробирки с посевами для окончательного учета ТКБ оставляют до 24 ч. Пробирки с посевами для подтверждения наличия ОКБ после просмотра через 24 ч и получения отрицательного результата оставляют для окончательного учета до 48 ч.
При лабораторно-производственном контроле качества воды поверхностных водоемов анализ может быть завершен подсчетом колоний, которые отнесены к ОКБ по двум признакам: отрицательному оксидазному тесту и ферментации лактозы на среде Эндо до кислоты и альдегида. Дальнейшее подтверждение ОКБ по способности образовывать газ на лактозных средах проводят только при отсутствии достаточно четкой дифференциации лактозоположительных колоний, при росте мелкоточечных или мелких плоских колоний, не характерных для колиформных бактерий, при небольшом опыте работы выполняющего анализ.
Учет результатов. Грамотрицательные колонии учитываются как ОКБ при отрицательном оксидазном тесте и ферментации лактозы при температуре 37 °С с образованием кислоты и газа.
Грамотрицательные колонии учитываются как ТКБ при отрицательном оксидазном тесте и ферментации лактозы при температуре 44 °С с образованием кислоты и газа.
При анализе питьевой воды, воды водоемов число колониеобразующих единиц ОКБ и ТКБ подсчитывают на всех фильтрах и выражают результат анализа в КОЕ на 100 мл воды.
Вычисление проводят по формуле:
где X – число колоний в 100 мл; V – профильтрованный через фильтры объем воды; а – число подсчитанных на этих фильтрах колоний в сумме.
Примеры:
- При посеве по 100 мл воды на 3 фильтрах выросло две колонии на одном фильтре, на остальных двух фильтрах нет роста. Число общих или термотолерантных колиформных бактерий будет:
- При посеве 10, 40, 100 и 150 мл воды на фильтрах с профильтрованным объемом 40 мл выросло 4 изолированные колонии, с профильтрованным объемом 100 мл – 3 ОКБ. Фильтры с объемами 10 и 150 мл заросли и учету не подлежат. Суммируют общее число колоний ОКБ (ТКБ) на тех фильтрах, где получены изолированные колонии, пересчитывают это число на объем 100 мл.
Питьевая вода, вода водоемов удовлетворяют требованиям в том случае, когда ОКБ и ТКБ не обнаруживают в 100 мл воды. При установлении бактериальной загрязненности воды свыше допустимых норм прибегают к повторному исследованию воды.
18.3.2. Определение общих и термотолерантных колиформных бактерий титрационным методом
Первый день: а) при исследовании питьевой воды засевают 3 объема по 100 мл (качественный метод). При исследованиях воды с целью количественного определения ОКБ и ТКБ при повторном анализе производят посев: трех объемов по 100 мл, трех объемов по 10 мл, трех объемов по 1 мл;
б) посев воды водоемов производят в двух или трех повторностях. Воду водоемов, не загрязняемых сточными водами, засевают в объемах по 10; 1; 0,1; 0,01 мл; воду водоемов, загрязняемых сточными водами, – по 1; 0,1; 0,01; 0,001 мл; воду водоемов в зоне влияния выпусков сточных вод – в объеме по 0,1; 0,01; 0,001; 0,0001 мл.
Каждый объем исследуемой воды засевают в лактозопептонную среду (рецепт 95). Посев 100 и 10 мл воды производят в 10 и 1 мл концентрированной лактозопептонной среды, посев 1 мл пробы проводят в 10 мл среды обычной концентрации.
Второй день. Посевы инкубируют при 37±1 °С. Не ранее 24 ч инкубации проводят предварительную оценку посевов. Из емкостей, где отмечено наличие роста (помутнение) и образование газа, производят высев бактериологической петлей на сектора среды Эндо (рецепты 96, 97) для получения изолированных колоний.
Емкости без наличия роста и образования газа оставляют в термостате и окончательно просматривают через 48 ч. Посевы без признаков роста считают отрицательными, и дальнейшему исследованию они не подлежат. Из емкостей, где отмечено помутнение и образование газа или только помутнение, делают высев на сектора среды Эндо.
Посевы на среде Эндо инкубируют при температуре 37±1 °С в течение 18–20 ч.
При образовании помутнения и газа в среде накопления и росте на среде Эндо колоний, типичных для лактозоположительных бактерий (темно-красных или красных, с металлическим блеском или без него, выпуклых с красным центром и отпечатком на питательной среде), дают положительный ответ на присутствие ОКБ в данном объеме пробы.
Отрицательный ответ выдается, если в среде накопления и на секторах среды Эндо не отмечено роста; на секторах среды Эндо выросли не характерные для колиформных бактерий колонии; все колонии оказались оксидазоположительными; все бактерии оказались грамположительными; не отмечено газообразования в подтверждающем тесте на среде с углеводом.
Для определения секторов среды Эндо, где выросли типичные лактозоположительные колонии, делают посев 2–3 изолированных колоний каждого типа с каждого сектора в пробирки с любой из лактозных сред (рецепты 99, 100).
Среду перед посевом нагревают на водяной бане или в термостате до 44 °С. Немедленно после посева пробирки помещают в термостат и инкубируют при температуре 44±0,5 °С в течение 24 ч. Допускается просмотр посевов через 4–6 ч.
При образовании газа в среде накопления, росте на среде Эндо лактозоположительных бактерий и выявлении способности этих бактерий ферментировать лактозу до кислоты и газа в течение 24 ч при температуре 44 °С дают положительный ответ на наличие в этом объеме пробы воды ТКБ. Во всех остальных случаях выдают отрицательный ответ.
Для ускорения выдачи ответа на присутствие ТКБ производят высев 1 мл из объемов среды накопления, где отмечено помутнение и газообразование в пробирке с лактозо-пептонной средой с поплавком и прогретой предварительно до температуры 44 °С. Посевы выдерживают в термостате при температуре 44±0,5 °С в течение 24 ч. При обнаружении кислоты и газа дают положительный ответ.
Учет результатов. При обнаружении ОКБ и ТКБ хотя бы в одном из трех объемов питьевой воды выдается ответ об обнаружении ОКБ и ТКБ в 100 мл.
При исследовании количественным методом определяют наиболее вероятное число (НВЧ) ОКБ и ТКБ питьевой воды (табл. 18.1), воды водоемов (табл. 18.2).
petritest.ru
Колиформные бактерии что это такое
Термотолерантные колиформные бактерии
Бактерии этого типа представляют собой группу колиформных организмов. способных ферментировать лактозу при 44 – 45 о С и включают род Escherichia (более известный как E.Coli ) и в меньшей степени отдельные виды Klebsiella, Enterobacter и Citrobacter.
Термотолерантные колиформные бактерии поддаются быстрому обнаружению и поэтому играют важную вторичную роль при оценке эффективности очистки воды от фекальных бактерий. Более точным индикатором служит именно E.Coli (кишечная палочка), так как источником некоторых других термотолерантных колиформ могут служить не только фекальные воды. Именно поэтому часто используемый термин фекальные колиформы некорректен и ВОЗ не рекомендует им пользоваться применительно к термотолерантным колиформным микроорганизмам.
Однако полная идентификация E.Coli слишком сложна для рутинных исследований. В то же время общая концентрация термотолерантных колиформ в большинстве случаев прямо пропорциональна концентрации E.Coli, а их вторичный рост в распределительной сети маловероятен (за исключением случаев наличия в воде достаточного количества питательных веществ, при температуре выше 13 о С и отсутствии остаточного хлора). Все это делает использование термотолерантных колиформных бактерий в качестве индикатора загрязнения воды весьма практичным.
ВОЗ рекомендует национальным контрольным лабораториям производить точное определение E.Coli в случаях обнаружения большого количества термотолерантных бактерий (при отсутствии санитарных аварий), либо, наоборот, в условиях, когда возможности комплексных микробиологических исследований ограничены.
Колиформные организмы (общие колиформы)
Колиформные организмы являются удобными микробными индикаторами качества питьевой воды и в этом качестве применяются уже много лет. Связано это, в первую очередь, с тем, что они легко поддаются обнаружению и количественному подсчету.
Термин Колиформные организмы (или колиформные бактерии ) относится к классу граммотрицательных бактерий, имеющих форму палочек, в основном живущих и размножающихся в нижнем отделе пищеварительного тракта человека и большинства теплокровных животных (например, домашнего скота и водоплавающих птиц) и способных ферментировать лактозу при 35-37 о С с образованием кислоты, газа и альдегида. В воду попадают, как правило, с фекальными стоками и способны выживать в ней в течение нескольких недель, хотя и лишены (в подавляющем большинстве) способности к размножению.
Исследования последних лет показывают, что наряду с традиционно относимыми к этому классу бактериями Escherichia (или E.Coli). Citrobacter, Enterobacter и Klebsiella (для которых справедливо все вышесказанное), к этому типу относятся и такие ферментирующие лактозу бактерии, как Enterobacter cloasae и Citrobadter freundii. Последние можно обнаружить не только в фекалиях, но и в окружающей среде (богатые питательные воды, почва, разлагающиеся растительные материалы и т.п.), а также в питьевой воде с относительно высокой концентрацией питательных веществ. Кроме того, сюда же относятся и виды, которые редко или совсем не обнаруживаются в фекалиях и могут размножаться в воде достаточно хорошего качества.
Вышесказанное означает, что возможности применения этой группы в качестве индикатора фекального загрязнения вод ограничено. Тем не менее, хотя колиформные организмы не всегда напрямую связаны с наличием в воде патогенных агентов, колиформный тест вполне применим для контроля микробиологического качества очистки воды, подаваемой в системы водоснабжения.
Согласно рекомендациям ВОЗ, колиформные бактерии не должны обнаруживаться в системах водоснабжения с подготовленной водой. Допускается случайное попадание колиформных организмов в распределительной системе, но не более чем в 5% проб, отобранных в течение любого 12-месячного периода при условии отсутствия E.Coli. Присустствие же колиформных организмов в воде свидетельствует о ее недостаточной очистке, вторичном загрязнении или о наличии в воде избыточного количества питательных веществ. При их обнаружении обязательным является тест на наличие термотолерантных колиформных бактерий (и/или E.Coli).
Бактериологические и паразитологические показатели качества воды – общие колиморфные бактерии
Консультанты
Антон Бударагин Консультант E-mail:[email protected] Тел.:(831)216-43-00 доб.129
Дмитрий Горащенков Консультант E-mail:[email protected] Тел.:(831)216-43-00 доб.104
Александр Осетров Консультант E-mail:[email protected] Тел.:(831)216-43-00 доб.131
Колиформные бактерии в воде
Для того, чтобы пить чистую воду, ее нужно, прежде всего, оценить на пример содержания разного рода включений. Даже вода из крана, может бать заражена бактериями. И причина тому, плохое состояние системы водоснабжения. Очень часто в воде, особенно неочищенной сегодня можно встретить всякого рода бактерии. А для того, чтобы вода стала питьевой, колиморфные бактерии в воде следует уничтожать.
Не должно быть в 20 мг воды
Как наглядно видно из таблицы, бактерий, практически не должно быть в воде. Любое присутствие колиформных бактерий в воде или каких других, может вызвать массовые эпидемии. Потому и поставлен запрет на их присутствие. Это может привести к летальному исходу многих людей.
Весь перечень вредных бактерий довольно обширен. Выявить все вредные бактерии в воде сложно, потому и придумали более современные методы анализов – химико-бактериологический, который и помогает выявить вредные палочные бактерии, в том числе. Эти вредоносные примеси можно выявить только в лаборатории. На вкус, цвет и вид выявить их невозможно.
Появляются такие бактерии в любом теплокровном существе. В том числе в кишечнике животных или человека. Откуда же они берутся в воде? Все просто, если в воду попадают фекалии, то развитие таких вредоносных бактерий очень возможно.
Фекалии же могут проникать в воду из сточных канав, выгребных ям, фильтровых траншей. Проявиться они могут даже в колодце. из-за смещения слоев грунта. Человек же эксплуатирующий колодец, может этого и не заметить. Потому и рекомендуют через время делать анализ воды в колодце, если нет качественной очистной системы на участке.
По санитарным нормам колиформных бактерий в воде не должно быть совсем. Потому на станциях водоснабжения всегда есть этап обеззараживания, который как раз и занимается устранением вредных бактериологических примесей.
Наиболее популярными вариантами устранения бактерий из воды являются обеззараживающие установки. Можно конечно и вручную дозировать дезинфицирующие вещества. Но это чревато плохими последствиями. Из-за этого на производствах давно убрали ручной труд в работе обеззараживающих установок.
Для устранения бактериологической угрозы на предприятиях используют дозирование химических веществ. Если вода будет использоваться для питья, то в этом случае применяют ультрафиолетовые дезинфекторы, которые работают без вредных веществ.
О бактериях научным языком и более подробно
Колиформные бактерии называются еще очень вредными. Это группа одна из самых вредных групп бактерий. Из семейства энтеробактерий, группу палочки культуральным признакам. Группа таких бактерий является санитарным показателем фекальных вод.
По порядку ниже будут исследованы следующие особенности поведения бактерий кишечной палочки:
- Поведение бактерий в плотной питательной среде
- Биохимические особенности
- Устойчивость
- Санитарные значения
Хотя данный вид информации довольно специфичен, но он помогает наглядно проследить все особенности работы бактерий в воде. На сколько они устойчивы, что вызывают своей работой в воде и т.д.

Итак, питательная среда. Бактерии прекрасно себя чувствуют в мясном бульоне или агаре. Осадок при этом имеет небольшие размеры, а вот рост бактерий резко идет вверх и появляется сильное помутнение воды.
Бактерии в бульене образуют окаемку, пленки при этом на поверхности нет. По цвету, большое скопление бактерий может иметь серо-голубой оттенок, иногда колонии могут быть красными с металлическим отливом. Колонии бактерий с отрицательной лактозой чаще всего бесцветны. В общем, же классифицировать по цветам и поведению бактерии группы палочки довольно сложно.
Теперь, что касается биохимических свойств. Бактерии такого рода помогают свертываться молоку, не разводят желатин. Оксидазной активности у них нет.
Расщеплять лактозу могут как раз бактерии кишечной палочки (с положительной лактозой).
Что касается устойчивости бактерий к разного рода химическим сильным дезинфекторам. Обезвредить кишечную палочку довольно просто. Для этого достаточно стандартной пастеризации при температуре 65, от силы 75 градусов. При температуре в 60 градусов по Цельсию, кишечная палочка убивается в течение 15 минут. Однопроцентный раствор фенола убирает палочку за период от 5 до 15 минут. Если разводить сулему в пропорциях один к тысячи, то тогда палочка будет убрана за 2 минуты. То есть убрать такие бактерии – не проблема.
Санитарные показатели бактерий кишечной палочки имеют разные значения. Если бактерии такого рода обнаруживаются на фруктах овощах в воде или почве, это означает только одно – свежее фекальное загрязнение имеет место.
Что характерно, в желудке человека, если он долгое время применяет антибиотики, тоже образуются бактерии кишечной палочки. Лактозоотрицательные бактерии в состоянии сбродить лактозы, именно они и образуются в большом количестве в кишечнике. Так образуются брюшной тиф, дизентерия, как раз те болезни, которые проявляют себя при употреблении зараженной кишечной палочкой воды.
Из всего вышесказанного, можно сделать вывод. Колиформные бактерии в воде должны полностью отсутствовать. Наличие их в воде угрожает эпидемиями и массовыми смертями. Чтобы избежать массового заражения, нужно постоянно следить за составом воды. Изменение потоков подземных вод, может привести к образованию грязных потоков.
Устранить колиформные бактерии из воды можно всего двумя способами. Использовать либо дезинфекцию, либо обеззараживание. Разница в понятиях состоит в воздействии. Оно может быть химическим, а может быть физическим. Для очистки сточных вод может использоваться химическое воздействие с помощью хлорсодержащих элементов. Но в этом случае обязательно должна проходить доочистка. Чтобы устранить из воды излишек хлора, который так же негативно влияет на здоровье человека.
Остальные варианты производства питьевой воды используют ультрафиолетовые излучатели, которые убивают группу бактерий кишечной палочки с помощью ультрафиолета. Не облучая при этом воду вредными лучами и не оставляя после себя следов.
Еще один вариант дезинфекции использование озона – концентрированного жидкого кислорода. Он быстро испаряется с поверхности воды, отлично чистит ее и не имеет остаточных явлений в воде. Полностью экологически безопасен. Но труден в производстве и дорог.
Бактерии в нашей воде
В разделе: Вода | и в подразделах: дезинфекция. | Автор-компилятор статьи: Лев Александрович Дебаркадер
Ранее, в разделе Вода и подразделе Дезинфекция мы затронули вопросы обеззараживания воды (например, в статье Реагентное обеззараживание воды ). И, кроме того, мы начали интересную тему, посвящённую тем, от кого мы обеззараживаем воду (см. статью Болезнь легионеров (легионеллёз) ). Но существует намного больше бактерий, которые живут в воде и от которых нужно защититься с помощью, например, ультрафильтрации. Поэтому наша сегодняшняя тема #8212 бактерии в нашей воде. Где мы расскажем немножко про то, какие бактерии не должны жить в нашей воде.
Бактерии в нашей воде #8212 это нежелательное явление по ряду причин, которые мы рассмотрим далее. Бактерии в целом определяются с помощью микробиологического анализа воды, и выражаются общим микробным числом с единицей измерения колоний образующие единицы , к.о.е. (или к.у.о на украинском языке, colony forming units #8212 CFU на английском языке).

Общее микробное число отражает общий уровень содержания бактерий в воде, а не только тех из них, которые образуют колонии, видимые невооруженным глазом на питательных средах при определенных условиях культивирования.
Бактерии в целом, выраженные общим микробным числом, включают несколько групп и подгрупп бактерий. Это:
- Колиформные бактерии (в том числе термотолерантные).
- Сульфитредуцирующие клостридии.
Кстати, в микробиологический анализ воды входит и определение вирусов (колифаги, вирусы, которые подавляют бактерий), и определение паразитов (например, лямблий).
Пара слов про клостридий. Клостридии #8212 это своеобразный эталон. Они очень живучи, или если по научному, устойчивы к обеззараживанию, что делает их своеобразным показателем – отсутствуют клюстридии, отсутствуют и другие, даже более опасные микроорганизмы.

И, наконец, обратим внимание на наиболее распространённый показатель #8212 на колиформные бактерии как один из камней преткновения при микробиологическом анализе воды.
Камень преткновения, кстати, состоит в том, что часто считается, что это болезнетворные бактерии, и если глотнуть такой водички, то дезинтерия или холера начинается почти сразу. Но по отношению к колиформным бактериям это не совсем так. Согласно определению из словаря,
Колиформные бактерии #8212 это бактерии группы кишечной палочки (БГКП, также называются колиморфными и колиформными бактериями) — условно выделяемая по морфологическим и культуральным признакам группа бактерий семейства энтеробактерий, используемая санитарной микробиологией в качестве маркера фекальной контаминации
На нормальном языке это означает, что все бактерии, похожие чем-то на бактерию Кишечная палочка (Escherichia coli, по имени Теодора Эшериха сокращённо E.coli), обЪединены в одну группу, названную колиформные бактерии , то есть, бактерии, похожие на E.coli . Кроме того, колиформные организмы являются удобными микробными индикаторами качества питьевой воды и в этом качестве применяются уже много лет. Связано это, в первую очередь, с тем, что они легко поддаются обнаружению и количественному подсчету.
Термин Колиформные организмы (или колиформные бактерии ) относится к классу граммотрицательных бактерий, имеющих форму палочек, в основном живущих и размножающихся в нижнем отделе пищеварительного тракта человека и большинства теплокровных животных (например, домашнего скота и водоплавающих птиц). Следовательно, в воду они попадают, как правило, с фекальными стоками и способны выживать в ней в течение нескольких недель, хотя и лишены (в подавляющем большинстве) способности к размножению.
- Соответственно, если данные бактерии находятся в питьевой воде, то это значит, что есть вероятность загрязнения воды сточными водами.
- Ну и во-вторых, если среди колиформных бактерий есть вирулентные штаммы (болезнетворные разновидности) бактерий, то возможно и возникновение заболеваний.
Кроме того, среди колиформных бактерий часто определяется ещё одна группа- термотолерантные колиформные бактерии. Это бактерии, которые похожи на Кишечную палочку , и способны переваривать пищу при более высоких температурах (44 #8212 45 о С) и включают собственно род Escherichia (более известный как E.Coli) и некоторые другие.
Термотолерантные колиформные бактерии выделяются в отдельную подргуппу в микробиологическом анализе, поскольку свидетельствуют о недавнем фекальном загрязнении. Кроме того, их относительно просто определить #8212 поэтому почему бы и не включить их в результаты анализа?
Как бы то ни было, любое повышенное содержание бактерий в воде #8212 это тревожный признак, и при его появлении нужно что-то делать с водой (например, начинать использовать фильтры ).

Итак, мы сделали общий теоретический обзор бактерий в нашей воде, и можем перейти к практике.
Иногда возникает такая ситуация: кто-то хочет провести микробиологический анализ воды. Отбирает пробу воды, относит в санэпидемстанцию, а там#8230 Тысячи и тысячи бактерий. Проблема состоит в том, что это не значит, что в исходной воде эти бактерии были. На самом деле есть три варианта их появления в пробе воды:
- бактерии действительно присутствуют в воде
- занесены в процессе монтажа оборудования и трубопроводов
- имел место неправильный отбор проб на микробиологию.
Для того, чтобы исключить третью причину избыточного количества бактерий в воде, нужно правильно отбирать пробу воды. Соответственно, предлагаем вашему вниманию важные правила по правильному отбору пробы воды для микробиологического анализа. Так, нужно:
- Использовать только бутылку предварительно обеззараженную в автоклаве.
- Перед отбором пробы помыть руки мылом.
- Носик крана, из которого будет произведен отбор, пробы необходимо протереть спиртом или обжечь пламенем от зажигалки или спички.
- Наполненную до верху водой бутылку отвезти в лабораторию как можно быстрее (например, в течение двух часов).
Поэтому можно сделать вывод: бактерий не должно быть в воде не только потому что они могут привести к болезням, а и потому что они #8212 индикатор загрязнения воды побочными продуктами (например, слишком много органики, фекальные воды и т.д.). Другими словами, эти данные не имеют большого значения для обнаружения фекального загрязнения и не должны считаться важным показателем при оценке безопасности систем питьевого водоснабжения, хотя внезапное увеличение числа колоний при анализе воды из подземного водоисточника может служить ранним сигналом загрязнения водоносного горизонта.
Соответственно, бактерии в нашей воде #8212 это не то, что там должно быть

Источники:
www.sferatd.ru
Найдены колиформные бактерии в питьевой воде
При исследовании воды питьевой на соответствие требованиям СанПиН 2.1.4.1074-01 специалистами отдела ветеринарно-санитарной экспертизы ФГБУ «Центральная научно-производственная ветеринарная радиологическая лаборатория» в 2 пробах обнаружены ОКБ (общие колиформные бактерии) и ТКБ (термотолерантные колиформные бактерии).
Санитарно-эпидемиологические правила и нормативы СанПиН 2.1.4.1074-01 «Питьевая вода. Гигиенические требования к качеству воды централизованных систем питьевого водоснабжения. Контроль качества.» применяются в отношении воды, подаваемой системами водоснабжения и предназначенной для потребления населением в питьевых и бытовых целях, для использования в процессах переработки продовольственного сырья и производства пищевых продуктов, их хранения и торговли, а также для производства продукции, требующей применения воды питьевого качества.
Колиформные бактерии
Для того, чтобы пить чистую воду, ее нужно, прежде всего, оценить на пример содержания разного рода включений. Даже вода из крана, может быть заражена бактериями. И причина тому, плохое состояние системы водоснабжения. Очень часто в воде, особенно неочищенной сегодня можно встретить всякого рода бактерии. А для того, чтобы вода стала питьевой, колиморфные бактерии в воде следует уничтожать.
Выявить бактерии в воде не так просто. Их не увидеть или не почувствовать на вкус. Любое присутствие колиформных бактерий в воде или каких других, может вызвать массовые эпидемии. Потому и поставлен запрет на их присутствие. Это может привести к летальному исходу многих людей. Брюшной тиф, дизентерия, как раз те болезни, которые проявляют себя при употреблении зараженной кишечной палочкой воды. Чтобы избежать массового заражения, нужно постоянно следить за составом воды.
Колиформные организмы уже давно считаются удобными микробными индикаторами качества питьевой воды, главным образом потому, что легко поддаются обнаружению и количественному определению.
Общие колиформные бактерии
Общие колиформные бактерии согласно СанПиНу должны отсутствовать в 100 мл питьевой воды.
Общие колиформные бактерии не должны присутствовать в подаваемой потребителю очищенной питьевой воде, а их наличие свидетельствует о недостаточной очистке или вторичном загрязнении после очистки. В этом смысле тест на колиформы может использоваться как показатель эффективности очистки. Известно, что цисты некоторых паразитов более устойчивы к обеззараживанию, чем колиформные организмы. В связи с этим отсутствие колиформных организмов в поверхностных водах не всегда свидетельствует, что они не содержат цист лямблий, амеб и других паразитов.
Термотолерантные фекальные колиформы
Термотолерантные фекальные колиформы согласно СанПиНу должны отсутствовать в 100 мл исследуемой питьевой воды.
Термотолерантные фекальные колиформы представляют собой микроорганизмы, способные ферментировать лактозу при 44 °С или 44,5 °С.
Вторичный рост фекальных колиформ в распределительной сети маловероятен, за исключением тех случаев, когда присутствует достаточное количество питательных веществ (БПК больше 14 мг/л), температура воды выше 13 °С, а свободный остаточный хлор отсутствует. Этот тест отсекает сапрофитную микрофлору.
Колиформы могут свидетельствовать о попадании в воду патогенных микроорганизмов. Кишечные патогенные болезни широко распространены во всем мире. Среди возбудителей, встречающихся в загрязненной питьевой воде, обнаруживают штаммы сальмонелл, шигелл, энтеропатогенной кишечной палочки, холерного вибриона, иерсинии, энтероколитики, кампилобактериоза. Эти организмы вызывают заболевания, варьирующие от легкой формы гастрита до тяжелых, а иногда и летальных форм дизентерии, холеры, брюшного тифа.
Другие организмы, естественно присутствующие в окружающей среде и не считающиеся патогенными агентами, могут иногда вызывать оппортунистические заболевания (т. е. заболевания, вызванные условно-патогенными микроорганизмами – клебсиелами, псевдомонадами и др.). Такие инфекции чаще всего возникают у лиц с нарушениями иммунной системы (местного или общего иммунитета). При этом питьевая вода, используемая ими, может вызвать самые различные инфекции, в том числе поражения кожи, слизистых глаз, уха, носоглотки.
Не подвергайте себя и своих близких опасности, употребляйте только проверенную воду!
www.fgu-radiovetlab.ru
термотолерантные колиформные бактерии – это… Что такое термотолерантные колиформные бактерии?
- термотолерантные колиформные бактерии
64 термотолерантные колиформные бактерии; термотолерантные колиформы: Бактерии, обладающие признаками общих колиформных бактерий, а также способные ферментировать лактозу до кислоты, альдегида и газа при температуре 44 °С в течение 24 ч.
Примечание – Индикаторная группа бактерий, указывающая на фекальное загрязнение воды
Словарь-справочник терминов нормативно-технической документации. academic.ru. 2015.
- Термостойкость пигмента
- термоукладка
Смотреть что такое “термотолерантные колиформные бактерии” в других словарях:
термотолерантные колиформные бактерии — Бактерии, обладающие признаками общих колиформных бактерий, а также способные ферментировать лактозу до кислоты, альдегида и газа при температуре 44 °С в течение 24 ч. Примечание Индикаторная группа бактерий, указывающая на фекальное… … Справочник технического переводчика
Колиформные бактерии термотолерантные — Термотолерантные колиформные бактерии бактерии, обладающие всеми признаками общих колиформных бактерий и способные ферментировать лактозу до кислоты и газа при температуре 44 С в течение 24 ч. Указывают на недавно попавшее в воду фекальное… … Официальная терминология
ГОСТ 30813-2002: Вода и водоподготовка. Термины и определения — Терминология ГОСТ 30813 2002: Вода и водоподготовка. Термины и определения оригинал документа: 65 Esherichia coli; E. coli: Аэробные и факультативно анаэробные термоустойчивые колиформные бактерии, которые ферментируют лактозу или маннитол при… … Словарь-справочник терминов нормативно-технической документации
ТКБ — токсикологическая безопасность Источник: http://npc.sarov.ru/issues/safetybook/chapter2p1.html ТКБ ТТКБ термотолерантные колиформные бактерии ТКБ ТрансКредитБанк ОАО http://www.tcb.ru … Словарь сокращений и аббревиатур
ТТКБ — ТКБ ТТКБ термотолерантные колиформные бактерии … Словарь сокращений и аббревиатур
normative_reference_dictionary.academic.ru
Вред для организма